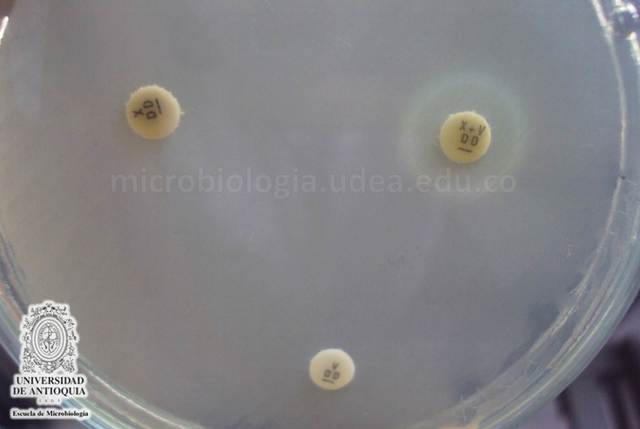
Charles Spearman

HISTORIA DE LOS ENFOQUES CUANTITATIVO, CUALITATIVO Y MIXTO: RAÍCES Y MOMENTOS DECISIVOS
-
Es difícil definir con precisión cuándo se inició el enfoque cuantitativo, más bien sus comienzos provienen de distintas fuentes y su evolución ha sido continua (algunos autores de la historia de la ciencia los ubican desde Aristóteles y otros en diferentes puntos de los siglos XVI, XVII y XVIII).
-
Acuñó el término en alemán “Statistik”
para referirse al análisis de los datos del Estado, en particular los censos poblacionales -
Éste tiene sus primeros cimientos con Immanuel Kant (siglo XVIII), quien señala básicamente que el mundo que
conocemos es construido por la mente humana. Las “cosas” en sí mismas existen, pero nosotros las apreciamos del modo como es capaz de percibirlas nuestra mente. -
Quien introduce el término verstehen o “entender”, reconoce
que además de la descripción y medición de variables sociales, deben considerarse los
significados subjetivos y la comprensión del contexto donde ocurre el fenómeno. -
Desarrolla las gráficas estadísticas como un mejor medio para representar los resultados (anteriormente se utilizaban tablas).
-
Propone la desviación media, y alrededor de esa época genera el análisis de la distribución normal y plantea la técnica de mínimos cuadrados que posteriormente derivarían en el análisis de varianza
-
El constructivismo como uno de los padres del enfoque cualitativo
los énfasis principales que lo caracterizan:Entre algunos de los autores que durante el siglo XX influyeron en el desarrollo del constructivismo tenemos a Mary Parker Follett (1868‐1933), en el campo de la Administración y las organizaciones; Jean Piaget (1896‐1980) y Lev Semenovich9Vygotsky (1896‐1934) en la Educación y John Dewey (1859‐1952) en la Pedagogía; así
como Margaret Mead (1901‐1978) en la Antropología. -
Presenta en la última década del siglo XIX: la moda (medida de tendencia central), una fórmula producto del momento de correlación, un procedimiento para calcular el tamaño de
muestra adecuado para representar a una población, la regresión lineal y múltiple (con la identificación de la capacidad para predecir puntuaciones mediante la información sobre la correlación entre las variables), así como el coeficiente de contin‐gencia
y la chi‐cuadrada -
A finales del siglo XIX ha nacido un pilar del enfoque
cuantitativo: la estadística. -
Trabajó sobre la correlación múltiple
-
Se desarrollan las primeras pruebas mentales con los esfuerzos de investigadores
-
A nuestro juicio, el enfoque cualitativo realmente se inicia como un proceso investigativo a finales del siglo XIX y sobre todo en el comienzo del siglo XX, aunque algunos arqueólogos realizaron estudios inductivos en la mitad del XIX.
-
Fundaron Biometrika, una revista que se dedicó al desarrollo de análisis estadísticos en el campo de la Biología
-
Discuten sobre la necesidad y valor del grupo de control en los experimentos.
-
presenta su coeficiente rho. Además por esos años se aplica el procedimiento para reducir variables denominado el análisis de factores y la prueba
-
La armada estadounidense, comienza a usar pruebas psicológicas
estandarizadas, particularmente durante la Primera Guerra Mundial -
Los diseños experimentales como los latinos
cuadrados de Thorndike. Además, las encuestas (surveys) incrementan su popularidad, William Anderson McCall concibe la
asignación al azar en experimentos y en 1917, F. Stuart Chapin pública sobre la experimentación en ciencias sociales -
se continúa el desarrollo de pruebas psicométricas y
de logro, así como la estadística inferencial (conclusiones de la muestra a la población) se comienza a utilizar y diversos procedimientos se fortalecen. McCall publica a mediados de esa década su famosa obra: Cómo experimentar en Educación. -
investigadores conocidos como la Escuela de Chicago
Albion Small, William Isaac Thomas, Florian Znaniecki y el filósofo George Herbert Mead. Por ejemplo, Thomas y Znaniecki publicaron una investigación en 1927 sobre los inmigrantes polacos, en la cual se utiliza la biografía de los participantes como
herramienta de recolección de los datos. Otros estudios se centraron en culturas específicas y grupos urbanos marginados. -
Realiza sus experimentos en la planta Hawthorne de la compañía
Western Electric, lo que da inicio a este tipo de estudios en las organizaciones. En la siguiente década, se desarrollan las pruebas de selección de personal y un sinnúmero de tests estandarizados en diferentes campos -
y a que la SegundaGuerra Mundial exigía estudios basados en mediciones y estadística para la industria bélica, de construcción e incluso la propaganda (Hernández Sampieri y Mendoza, 2008);
aunque se realizaron algunos trabajos etnográficos de investigadores como Elizabeth y Allison Davis, y Burleigh y Mary Gardner, que estudiaron las clases sociales en Natchez -
La investigación cuantitativa se encuentra en su
apogeo, surgen diversas encuestas, experimentos, revistas científicas, diseños, etcétera.También comienzan a desarrollarse las máquinas para calificar pruebas y la computadora. -
Cabe destacar que la investigación‐acción comienza a desarrollarse en esta etapa (1945‐1955) con nombres como John Collier, Ronald Lippitt y Marian Radke y Stephen Maxwell Corey. Todos ellos siguieron a quien muchos autores consideran el
fundador formal de tal visión, Kurt Lewin -
Generan una tipología sobre los estudios experimentales,
Profesor Fred Kerlinger identifica tipos de diseños cuantitativos y fortalece el enfoque respectivo. una concepción que explica cómo los ítems difieren en dificultad y discriminación (teoría de las respuestas a los ítems) Surgen una gran cantidad de textos de estadística. Los programas de análisis de datos se desarrollan, particularmente el Paquete Estadístico para las Ciencias Sociales (SPSS). -
El enfoque cualitativo recobra vitalidad e importancia. La
etnometodología surge con vigor. Peter L. Berger y Thomas Luckmann en 1966 presentan sus modelos de construcción de la realidad (Berger y Luchmann, 1966). Dos sociólogos Barney G. Glaser y Anselm L. Strauss—, con pacientes en estado terminal
en el San Francisco Medical Center de la Uni de California, realizan diversos estudios y de sus experiencias publican el libro Discovery of grounded theory (1967), así emerge la Teoría Fundamentada -
Reanaliza el concepto de triangulación. Egon G. Guba consolida la
propuesta de un enfoque alternativo, el naturalista (1978). La teoría Fundamentada continúa evolucionando. Herbert Blumer desarrolla el interaccionismo simbólico -
En la última década del siglo XX surgen mediciones y análisis multivariados, se consolida la idea de “poder de medición” mediante la utilización de diferentes instrumentos para medir las variables de la investigación. Los programas de análisis se sofistican y comercializan. se cuenta con gran cantidad de escalas y posibilidades de análisis avanzados y diversos.Y es aquí donde ahora estamos. Cabe señalar que el primer enfoque de la investigación en desarrollarse completamente fue el cuantitativo.
-
se identifican diversos modelos causales multivariados (por ejemplo, el modelamiento de ecuaciones estructurales), se desarrolla el metaanálisis (técnica para analizar datos provenientes de distintos estudios con mediciones similares)
John W. Tukey empieza con el análisis exploratorio de datos -
Hacia el final de la primer década del siglo surgen textos de metodología cualitativa aplicada a diferentes disciplinas: Relaciones Públicas y Mercadotecnia (Daymon, 2010), Geografía Humana (DeLyser et al., 2009) y Educación (Luttrell, 2009),
solamente por mencionar algunas. Y aquí estamos. -
A partir de 2000, es un hecho que pocos dudan ya de lo valioso del enfoque cualitativo. Clandinin y Connelly (2000) revitalizan los diseños narrativos; mientras que Kemmis y McTaggart (2000) hacen lo mismo con la investigación participativa. Los diferentes marcos conceptuales cualitativos comienzan a integrarse en diseños con autores como Álvarez Gayou (2002) y Creswell (2005).
A list shows items. A timeline shows sequence.
Use Timetoast to make dates, milestones, and turning points easier to understand in a clear visual format. Timetoast is a timeline maker for work, school, research, and stories.